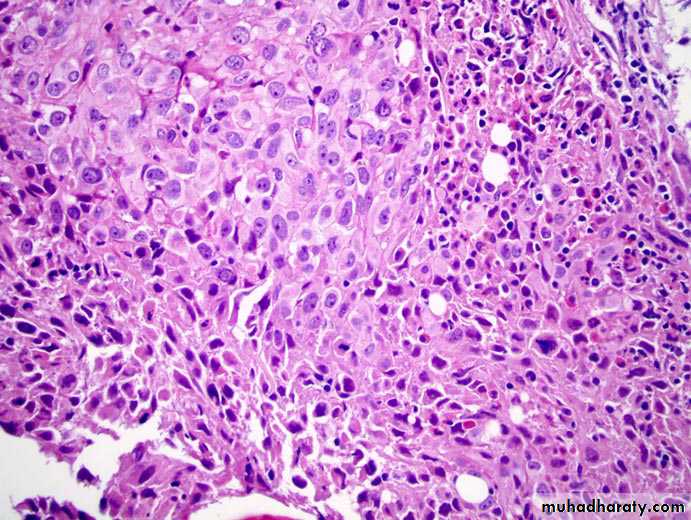

Aneurysm:-
Definition:- Aneurysms are congenital or acquired dilations of blood vessels or the heart .Atherosclerotic aneurysm:-
Which's usually occur in the abdominal aorta below renal arteries, its etiology occur due to genetic defects in connective tissue component for strength of blood vessels in atherosclerotic and hypertensive which will cause weakness of aortic wall, in atherosclerosis the aneurysm results from ECM degradation mediated by proteolytic enzymes released from inflammatory infiltrates in atherosclerotic lesions,.
This is take the form of saccular (ballon-like), cylindroid or fusiform swellings sometimes up to 15 cm in greatest diameter and to 25 cm length. It's complicated by thrombus formation in the wall and even rupture.
Vascular tumors:
It's divided into benign and malignant vascular tumor with intermediate grade between the two.Benign tumors:-
The most common benign tumor of blood vessel is hemangioma which's also divided into types: Cavernous and capillary hemangioma.
Capillary hemangioma:-
It's occur in skin, subcutaneous tissue or mucous membrane of oral cavity and lips, it appear as bright red to blue lesion, it's slightly elevated and even pedunculated, occasionally the hemangioma takes the form of large, flat, map-like discoloration that cover large areas of face or upper parts of body producing port wine stain.Microscopically, it consists of un-capsulated closely packed capillaries separated by a scant connective tissue stroma, the endothelium is usually plumpy but no a typia present. The channels filled by fluid or thrombosed blood . In the skin and mucous membrane, it may cause traumatic ulceration and bleeding.
Angiosarcoma:-
Microscopically appear as masses of anaplastic cells with few poorly formed vascular channels or may be not seen and in this case, it cannot be differentiated from other malignant soft tissue tumor as fibrosarcoma or leiomyosarcoma only by immunohistochemical study.These 2 malignant tumors distruption in the same location of benign tumor but it's usually larger, more solid, less obviously vascular and more invasive, there is special type of angiosarcoma called Kaposi's sarcoma, the type of epidemic KS seen in AIDS patients.
The heart:-
Most common diseases of heart are:-(I) Ischemic heart disease:-
It's a group of closely related syndromes cause by an imbalance between the myocardial oxygen demand and blood supply.
The most common cause of ischemic heart disease is a reduction in coronary arterial blood supply due to I- atherosclerosis of coronary arteries. Ischemic heart disease is responsible for about one third of all deaths.
Depending on the rate and severity of coronary artery narrowing and the myocardial response. One of the 4 syndromes may develop:-
1- Various forms of angina pectoris (chest pain).
2- Acute M.I.
3- Sudden cardiac death.
4- Chronic ischemic heart disease with congestive heart failure.
These syndromes are late manifestations of coronary atherosclerosis that probably begins during childhood.
Pathogenesis:-
Symptomatic ischemic heart disease is associated with reduction reached 75% or more of one or more coronary arteries by atherosclerotic plaque.
Acute coronary syndrome:
In addition to chronic fixed atherosclerotic plaques various superimposed lesions also play an important role in the development of myocardial ischemia, these include:
1- Acute changes in plaque morphology.
2- Platelets aggregation.
3- Coronary artery thrombosis.
4- Coronary artery vasospasm.
(II) There are other minor causes
decrease blood flow through coronary arteries as:
1- Emboli originating from vegetation on aortic or mitral valves.
2- Coronary vasculitis.
3- Severe systemic hypotension.
(III) There are factors increased myocardial oxygen demand also cause myocardial ischemia, as in:
1- Left myocardial hypertrophy.
2- Hypertension.
3- Diseases of heart valves.
Angina pectoris:
The term angina pectoris refers to presence of intermittent chest pain caused by reversible myocardial ischemia.
Myocardial infarction:
Definition: It's a single most common cause of death which's consisting of development of a defined area of myocardial necrosis caused by local ischemia.
Risk factor of M.I are the same of atherosclerosis.
Pathogenesis:
Most acute M.I are caused by preexisting atherosclerosis with thrombosis. This thrombosis occur usually on nidus of fissure formation on the plaque, however vasospasm and platelets aggregation may contribute to coronary artery occlusion.
Myocardial necrosis begins within 20 to 30 minutes of time of coronary artery occlusion. The myocardial infarcts typically begin with subendocardial region, because: a-it's the last area to receive blood from branches of the epicardial coronary arteries.
b- the relatively high intramural pressures that exist in this area.
The zone of necrosis extends externally over the next several hours to involve mid and subepicardial areas of myocardium.
The infarct usually reach the full size within 3 to 6 hours, so that during this period lysis of thrombus by administration of thrombolytic agents as tissue plasminogen activator may limit the size of infarct.
The location of M.I is determined by the site of the occlusion and by the anatomy of coronary circulation .e.g. occlusion of left anterior descending coronary artery cause infarction of anterior and apical areas of left ventricle, occlusion of the right coronary artery is responsible for most infarcts involving the posterior and basal portions of left ventricle.
The size of infarct is influenced by several factors e.g. occlusion of more proximal segments of the coronary arteries products larger infarcts involving the full thickness of myocardium, while occlusion of more distal arterial branches cause smaller infarcts, also in long standing coronary atherosclerosis, collateral circulation may develop over time in response to chronic ischemia, this collateral limit the size of infarct.
Morphology:-
The changes occur is that of coagulative necrosis and inflammation followed the formation of granulation tissue, resorption of the necrotic myocardium and finally organization of the granulation tissue to form a fibrous scar.The morphological changes associated with M.I for the first 12 hours no changes are evident on gross examination , between 18-24 hours a slight pallor may be noted .
Microscopically: Coagulative necrosis become apparent by about 12 to 18 hours so the myocytes become necrotic and having eosnophilic cytoplasm with loss of cross striation , the nuclei begin to undergo fragmentation (karyorrhexis) or pyknosis, neutrophils are attracted by the necrotic myocardium.
Chronic ischemic heart disease (ischemic cardiomyopathy)
It is a progressive congestive heart failure as a consequence of long term ischemic myocardial injury, it is associated with a history of angina pectoris and may be preceded by recognized infarctMorphology: The coronary arteries contain areas of moderate to severe atherosclerosis, the heart is enlarged due to dilation of all cardiac chambers , multiple areas of myocardial fibrosis with transmural scarring .
Microscopically:
Reveals extensive myocardial fibrosis due to chronic ischemia.
Sudden cardiac death:
Sudden cardiac death is form the major cause of Sudden death, and the most common cause of sudden cardiac death is ischemic heart disease because chronic ischemia predisposes the myocardium to the development of lethal ventricular arrythemias as ventricular fibrillation.Morphology: The most common cardiac lesions in sudden death are those of coronary atherosclerosis and it's complication the degree of atherosclerosis is marked with more than 75% reduction in lumen of 2 or more vessels, the acute plaque rupture followed by coronary thrombosis and possibly vasospasm triggers fatal ventricular arrythmias in most cases.
Cor pulmonale:
Or pulmonary heart disease is a disease of right sided cardiac chambers caused by pulmonary hypertension resulting from pulmonary parenchymal or vascular diseases.
The condition may be acute or chronic, acute cor pulmonale caused mostly from pulmonary embolism, chronic cor pulmonale the most common cause is chronic obstructive lung disease.
Morphology: In acute cor pulmonale the right ventricle is usually dilated, but if sudden death occur after massive pulmonary embolism the heart may appear normal in size . Chronic cor pulmonale is characterized by right ventricular and right atrial hypertrophy.